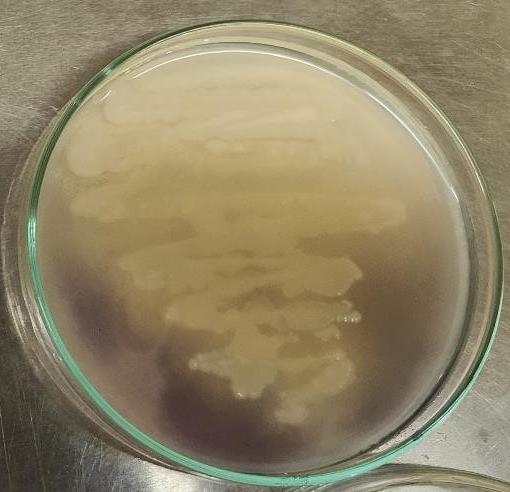
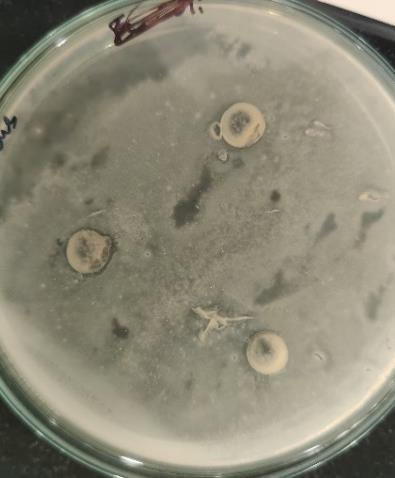
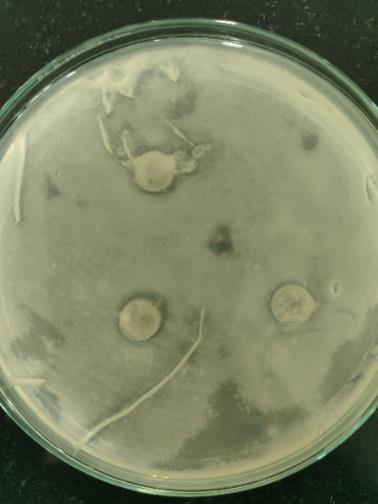
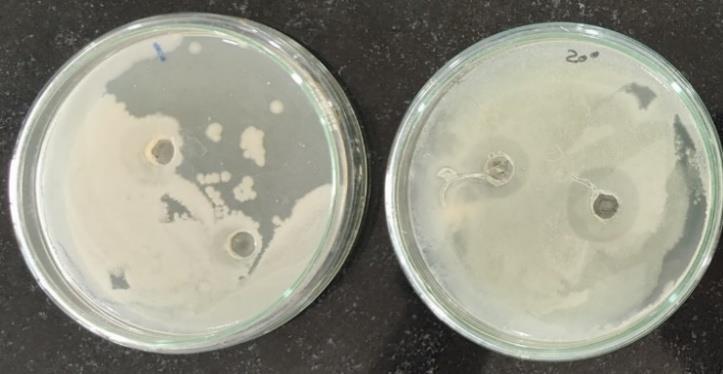
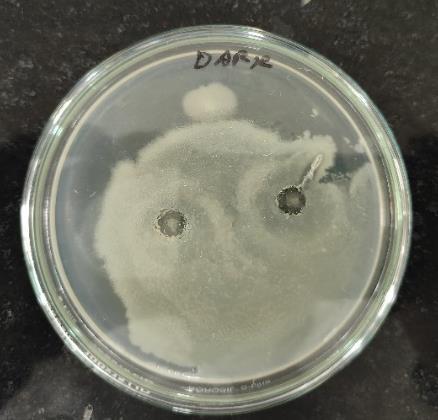
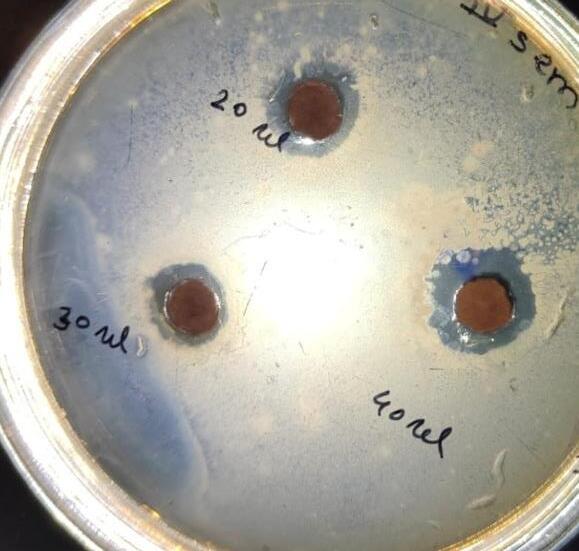

International Research Journal of Engineering and Technology (IRJET) e-ISSN:2395-0056
Volume: 12 Issue: 04 | Apr 2025 www.irjet.net p-ISSN:2395-0072


International Research Journal of Engineering and Technology (IRJET) e-ISSN:2395-0056
Volume: 12 Issue: 04 | Apr 2025 www.irjet.net p-ISSN:2395-0072
Dikshant Ravindra Khanderao1 , Tejaswini Balkrishna Bawane2, Ravindra Kale3
1,2Department of Biotechnology, Institute of Bioscience and Technology, MGM University, N-6, Cidco, Chhatrapati Sambhajinagar – 431003, Maharashtra, India.
3Assistant Professor, Department of Biotechnology, Institute of Bioscience and Technology, MGM University, N-6, Cidco, Chhatrapati Sambhajinagar – 431003, Maharashtra, India. ***
Abstract - Antibiotics, primarily derived from microorganisms, are essential in both medicine and agriculture. However, extensiveuse has culminated in antibiotic resistance, thus rendering it essential to study a variety of microbiological sources for the purpose to identify additional bioactive compounds. This study focuses on the isolation, identification, and optimization of bacteria producing secondary metabolites with antibiotic potential. A Gram-negativebacterial colony with antibiotic activity againstthetestmicroorganismEscherichiacoliwasidentified after soil samples collected from the university campus. Its identityhasbeenconfirmedthroughbiochemicalanalysis;the bacteriawerelateridentifiedasEscherichiafergusoniiby16S rRNA sequencing. Slight zones of inhibition against Staphylococcus aureus and E. coli have been identified during primary screening, indicating the potential of producing secondary metabolite. Optimization examinations were carried out, and analyzing parameters like pH, temperature, incubation time,light and dark conditions. Alteration in pH and incubation duration had no influence on antibacterial activity, whilelower temperatures andincubation under dark conditionssignificantlyimprovedit,basedontheresults.After fermentation, 0.071 g of brown crude extract enriched with secondary metabolites was extracted by butanol extraction. Antibacterial activity using the agar-well diffusion method indicate concentration-dependent activity against S. aureus. Zones of inhibition increased with higher metabolite concentrations; 0.2 mm for 20 µl, 0.25 mm for 30 µl, and 0.45 mm for 40 µl. This study shows that it is possible to isolate bacteria that produce antibiotics and maximize the production of their secondary metabolites; E. fergusonii exhibitsanabilitytoproducemetabolites.
Keywords: Antimicrobial activity, Escherichia fergusonii, Optimization, Secondary metabolites, 16s rRNA sequencing.
"Antibiotic," which comes from the Greek term antibiosis, meaning "against life," underlines its
effectiveness. The drug works by preventing bacteria from growing. Antibiotics are primarily generated by fermenting microbial cells, whether they are naturally occurring or artificially developed compounds. These compounds have a crucial roleincontrollingmicrobial populationsina variety of natural circumstances, such as soil, water, wastewater, and composting. Only a small number of the numerous antibioticsthathavebeendevelopedhavebeenshowntobe both safe and effective enough for application in medicine; most of them originate from microorganisms that belong to genera like Bacillus, Streptomyces, Penicillium, Cephalosporium, and Micromonospora. Remarkably, of the 5,000 known antibiotics that have been derived from bacteria, fungi, and plant cells, Streptomyces accounts for over60%(Awaisetal.,2007).
Despitetheirfundamentalsignificance,theextensiveand often excess of antibiotics in wastewater treatment, livestock, and aquaculture is resulting in an enormous increase in antibiotic residues in the environment. This contributes significantly to the formation of drug-resistant microbialpopulations(Nairetal.,2022).Modernantibiotics must be discovered and produced immediately to combat antibioticresistantailments.
Duringanattemptatfindingnewantibiotics,researchers are currently investigating a variety of microbiological sources due to the increasing prevalence of antibiotic resistance globally. They are among the most alluring alternatives because of their broad production of bioactive compounds. This study contributes to this field by identifyingandcharacterizingbacterialstrainsthathavethe potentialtoproduceantibiotics.(Kumarietal.2013)
The potential for pathogenicity and distinctive biochemical characteristics, such as being sorbitol negative and adonitol positive, have brought attention to Escherichia fergusonii, a lesser known member of the Escherichia genus (Glover et al., 2017). As a recently identified pathogen with multidrug resistance, E. fergusonii, initially isolated from primates other than humans, poses a significant safety concern.

International Research Journal of Engineering and Technology (IRJET) e-ISSN:2395-0056
Volume: 12 Issue: 04 | Apr 2025 www.irjet.net p-ISSN:2395-0072
This research project proposes to characterize the antibiotic resistance characteristics of E. fergusonii by focusing on understanding its resistance mechanisms and their function within the broader framework of microbial diversity and antibiotic discovery. By analyzing the connections between factors affecting the environment, microbial behavior, and resistance characteristics, this research aims at improving current attempts to combat antibiotic resistance while discovering possible novel antimicrobialapproaches.
2.1 Collection of samples and isolation of microorganisms
Collection of soil sample from university campusand to make it possible to process soil samples, 1 g of the test samplewasdissolvedin10mlofsteriledistilledwater,and then further serial dilutions were performed. Every dilution's 100 µl of supernatant was then spread across nutrient agar plates and kept overnight at 37°C. A test microorganism was introduced to each plate and incubated for48hours.Azoneofinhibitionwasthendetectedoneach plate, and colonies were selected to proceed with isolating testing.Toisolatethebacteria,selectedcolonieswereplated directly onto nutrient agar based on their morphologyand zone of inhibition. Distinct bacterial colonies were chosen based on colony characteristics and streaked on new agar plates during an overnight incubation. After that, the plates werestoredfor24hoursat37°C.Purifiedbacterialcultures were obtained on nutrient agar plates using the multiple streak platemethod.Following a 24-hourincubationperiod at 37°C, pure single colonies have been observed (Salim et al.2017).
Following the isolation of microorganisms, identification tests were conducted according toBergey's Manual regulations. The isolated strains were adequately identified and classified by using this technique (Buchanan et al 1974).
2.2.1
AloopfullofCulturewasplacedonacleanglassslide.To ensure adherence, the smear was heat-fixed. After adding crystal violet to the smear, it was let to sit for 30 to 60 secondsbeforebeingrinsedwithwater.Thesmearwasthen covered with Gram's iodine for a minute and then rinsed with water another time. The smear was then rinsed with water after being cleaned for 10–20 seconds with 95% alcohol or acetone. After adding safranin and allowing it
remain for approximately a minute, the smear underwent another water rinse. After being blotted and allowed to air dry,theslidewasexaminedunderamicroscope(Baileyand Scotts,1966).
2.3.1
1% Kovács oxidase reagent was used to soak a small pieceoffilterpaper,whichwasthenlettodry.Usingafresh bacterial plate that had been cultured for 18 to 24 hours, a well-isolated colony was selected using a loop and smeared onto the whatmen filter paper. A careful examination for color changes was noted. When the microorganisms turned dark purple in 5–10 seconds, they were determined to be oxidasepositive(Al-Rubayeetal.2023).
A hydrogen peroxide bottle and a glass slide were obtained. A small number of bacteria were applied to the driedslideusingasterileinoculatingloop.Afterthat,adrop of hydrogen peroxide was added to the bacterium (AlRubayeetal.2023).
2.3.3
There wasa tiny quantity ofa pure cultureadded to the tryptonebrothtube.Afterthat,itwasincubatedfor24to48 hours at 37°C. 5drops of Kovács reagent were added directly to the tube to examine for the production of indole (Al-Rubayeetal.2023).
Test tubes were used to prepare the MRVP broth. Two loopfuls of the respective bacterial cultures were added to the broth aseptically. The organism that was introduced appearedonthelabelsofthetesttubes.Afterthat,theywere incubated for 48–72 hours at 37°C. A few drops of methyl red indicator have been added to the incubated tubes after incubation, and results were observed (Al-Rubaye et al. 2023).
The broth was introduced with well-isolated colonies of sample bacteria from cultures that were 18 to 24 hours old using a sterile inoculating loop. After that, the tubes were incubated at 37°C for 18 to 24 hours. 2 ml of broth have been transferred to a sterile test tube after incubation. Reagent A (5% α-naphthol solution) was then added in 67drops and thoroughly incorporated by shaking. 2-3 drops of Reagent B (40% KOH solution) were then added, and

International Research Journal of Engineering and Technology (IRJET) e-ISSN:2395-0056
Volume: 12 Issue: 04 | Apr 2025 www.irjet.net p-ISSN:2395-0072
everything was thoroughly mixed by shaking. Within 30 minutes,thetubeswereexaminedtoseewhetherareddishpink color developed at the medium's surface. The tubes wererapidlyshakencontinuouslyforthedurationofthe30minutewaitingperiod(Al-Rubayeetal.2023).
A single streak inoculation of the organism to be investigatedwasmadeintothecenteroftheselectedplates using a sterile technique. Following inoculation, the plates were incubated for 48 hours at 37°C. After incubation, a dropper was used to saturate the surface of the plates with iodine solution for 30 seconds. They poured out the remaining iodine. The clear zone surrounding the bacterial growth line on the plates was observed (Al-Rubaye et al. 2023).
2.4
The process of 16S rRNA sequencing for bacterial identification began with the selection of a bacterial colony from the isolate. Polymerase chain reaction (PCR) with universal primers was used to amplify the 16S rRNA gene, and gel electrophoresis was used to verify the amplificationefficacy. To provide high-quality input for sequencing, the PCR product was then filtered. Each primer's sequencing trace files were produced through Sanger sequencing, and the accuracy of the traces was confirmed by quality control (QC) checks. A consistent sequencerecordwasgeneratedfromthesequencingtraces, andsubsequentqualitycontrolwasperformedtoensureits integrity. To determine the bacterial strain based on sequence similarity, the assembled sequence was subsequently submitted to BLAST database searches. Finally, the method of classification was verified by phylogeneticanalysis.
The agar well diffusion method was used to determine theantimicrobialactivityoftestpathogenicmicroorganisms, such as Staphylococcus aureus and Escherichia coli. After monitoring the inhibitory zones, only the isolated isolates showing broad-spectrum behavior have been selected for furtherexamination(Kumari,etal.,2013).
The isolates were inoculated into a 250 ml Erlenmeyer flask with 100 ml of Soybean Casein Digest Medium (TryptoneSoya Broth)totestgrowthandthe productionof antimicrobial compounds. The filtrate was then examined
for antibacterial activity using the agar well diffusion method(Khattabetal.,2016).
Using flasks containing 50 mlof Soybean Casein Digest Medium(TryptoneSoyaBroth),thepHwasvariedto6.5,7, and7.5inordertodeterminetheoptimumpHvalueforthe production of antimicrobial compounds. After inoculating the broth medium with isolated bacteria, the flasks were shaken and incubated for 7days at 30°C. Following incubation, the antibacterial activity of the supernatant was examined(Khattabetal.,2016).
The bacterial isolates were inoculated in optimized medium and incubated at various temperatures (0, 20, 30, and 40°C) for 7 days. After incubation, the supernatant was testedforantimicrobialactivity(Khattabetal.,2016).
2 flasks containing the bacterial culture media were incubated for 7 days under light and dark conditions. After incubation, the supernatant was tested for antimicrobial activity(Khattabetal.,2016).
2.6.4 Optimum incubation period
The culture was incubated in growth media for 10 days inordertodeterminetheeffectoftheincubationperiod.On days 4, 5, 6, 7, 8, 9, and 10, the broth was subjected to a series of tests for antibacterial activity using the disc diffusion method. After measuring the inhibition zones, the ideal incubation time was established for subsequent studies(Khattabetal.,2016).
The selected bacterial strain isolates were added to Tryptone Soy Broth and allowed to ferment for seven days at 30°C in a shaker. After fermentation, a Millipore filter (Millipore Millex-HV Hydrophilic PVDF 0.45 μm) was used tofilterthefiltrate,whichwasseparatedbycentrifugationat 5000 rpm for 10 minutes. For subsequent tests, the filtrate was aseptically transferred into a conical flask and kept at 4°C(Khattabetal.,2016).
2.8 Solvent extraction and purification of secondary metabolite compound
Afteraddingthesolventina1:1(v/v)ratiotothefilter,it was vigorously stirred for 20 minutes. A separating funnel

International Research Journal of Engineering and Technology (IRJET) e-ISSN:2395-0056
Volume: 12 Issue: 04 | Apr 2025 www.irjet.net
was used to separate the antibiotic-containing butanol phasefromtheaqueousphase.Methanolwasusedtopurify the residue, which produced dark crude extract, after the butanol layer was concentrated by drying out at 110°C.
Afteraddingthesolventina1:1(v/v)ratiotothefilter, itwasvigorouslystirredfor20minutes.Aseparatingfunnel was used to separate the antibiotic-containing butanol phasefromtheaqueousphase.Methanolwasusedtopurify the residue, which produced dark crude extract, after the butanol layer was concentrated by drying out at 110°C. Using the agar well diffusion method, this compound's antibacterial effectiveness against test pathogenic bacteria was determined. After 12–16 hours at 4°C, the plate was incubated for the entire night at 37°C. The test microorganism’s inhibition zones around the wells were measured(Khattabetal.,2016).


p-ISSN:2395-0072
Using the agar well diffusion method, this compound's antibacterial effectiveness against test pathogenic bacteria wasdetermined(Khattabetal.,2016)
Soil samples were collected from the roots of plants in a university campus(Fig. 1). For the isolation of microorganisms, 1g of soil was measured and added into 9 ml of sterile distilled water. Further serial dilutions were performed up to 7 test tubes. Then, the last four test tubes (10-4, 10-5, 10-6, 10-7 diluted samples) in amounts of 100 μl werespreadonnutrientagarplatesandkeptforincubation for24hours(Fig.2).Aftertheincubationperiod,theresults obtained revealed the growth of different colonies on the agarplates.Subsequently,wechecked whetherthecolonies were producing antibiotics or not by adding the test organism (E. coli). Among the different isolated colonies, only one showed a clear zone of inhibition against the test organism(Fig.3)andthentheywerestreakedonagarplates forprimaryscreeningtoobtainapureculture


International Research Journal of Engineering and Technology (IRJET) e-ISSN:2395-0056
Volume: 12 Issue: 04 | Apr 2025 www.irjet.net p-ISSN:2395-0072
3.2.1 Gram’s staining
A loopful of bacterial culture was placed to a cleaned glassslide,allowedtoheat-fix,andthensuccessivelytreated withsafranin,alcohol,Gram'siodine,andcrystalviolet.After being allowed to air dry, the slide was examined under a microscope. The bacterium appeared pink in color, indicating a Gram-negative bacterium, with rod-shaped structures(Fig.4).

3.3.1 Oxidase test
After being immersed in 1% Kovács oxidase reagent, a small piece of filter paper was allowed to dry. Using a new bacterial plate that had been cultured for 18 to 24 hours, a well-isolated colony was selected using a loop and rubbed onto the whatmen filter paper. A slight dark purple coloration appeared within 5-10 seconds, indicating a positiveoxidasetestresult.
3.3.2 Catalase test
A hydrogen peroxide bottle and a glass slide were acquired. A small number of bacteria were applied to the dried slide using a sterile inoculating loop. The bacteria were then covered with a drop of hydrogen peroxide A positive catalase reaction was shown by the immediate bubbleformationthatwasobserved(Fig.5)

3.3.3 Indole test
Asmall quantityofa pureculturehasbeenaddedtothe tryptone broth tube as the inoculation. After that, it was incubated for 24 to 48 hours at 37°C. 5drops of Kovács reagent were added directly to the tube to examine for the production of indole. A dark brown-colored ring formed on the broth surface, indicating a positive indole production result(Fig.6)

test
Test tubes were used to prepare the MRVP broth. 2loopfuls of the respective bacterial cultures have been introduced to the broth aseptically. The organism that was introduced was listed on the labels of the test tubes. After that, they were incubated for 48–72 hours at 37°C. A few dropsofmethylredindicatorwereappliedtotheincubated tubes after incubation. The appearance of the color red indicatedapositivemethylredtestresult(Fig.7)

International Research Journal of Engineering and Technology (IRJET) e-ISSN:2395-0056
Volume: 12 Issue: 04 | Apr 2025 www.irjet.net

Fig. 7 Apositivemethylredtestresultwasindicatedbythe appearanceofaredcolor.
The broth was introduced with well-isolated colonies of sample bacteria from cultures that were 18 to 24 hours old using a sterile inoculating loop. After that, the tubes were incubated at 37°C in the presence of oxygen for 18 to 24 hours. 2 ml of broth were moved to a sterile (ideally) test tube after incubation. Reagent A (5% α-naphthol solution) was then added in 6-7drops and thoroughly mixed by shaking. 2-3 drops of Reagent B (40% KOH solution) were then added, and everything was thoroughly mixed by shaking. Within 30 minutes, the tubes were examined to determine whether a reddish-pink color developed at the medium's surface. Throughout the 30-minute waiting period, the tubes were continuously shaken vigorously. A brownish-red coloration appeared on the surface of the broth within 30 minutes, confirming a positive VogesProskauertestresult(Fig.8).

8 A
p-ISSN:2395-0072
The organism to be studied was inoculated into the center of the labeled plates in a single streak using a sterile technique.Afterthat, the bacteriallyintroducedplates were incubated at 37°C for 48 hours. After incubation, a dropper wasusedtosaturatetheplates'surfacewithiodinesolution for30seconds.Theextraiodinehadbeeneliminatedout. A clear zone around the bacterial growth was observed, indicating starch degradation, while the remaining starch reactedwithiodinetoproduceadarkbrowncoloration(Fig. 9)
Fig. 9 Aclearzonearoundthebacterialgrowthwas observed,indicatingstarchdegradation,whilethe remainingstarchreactedwithiodinetoproduceadark browncoloration.

International Research Journal of Engineering and Technology (IRJET) e-ISSN:2395-0056
Volume: 12 Issue: 04 | Apr 2025 www.irjet.net
1. IndoleTest
2. Oxidasetest
3. Catalasetest
4. Methylred
5. Voges-Proskauertest
6. Starchhydrolysis
p-ISSN:2395-0072
Footnote: indicates a positive test result, confirming the presence of the respective biochemical reaction. indicates a negativetestresult,showingtheabsenceofthereaction.
The bacterial strain was identified as Escherichia fergusonii through 16S rRNA sequencing (Table 2). PCR amplification of the 16S rRNA gene was verified by gel electrophoresis, and Sanger sequencing produced highquality trace files (Fig. 10 & 11). The assembled sequence showed high similarity in BLAST analysis, and the identificationwasconfirmedbyphylogeneticanalysis(Fig. 12).



International Research Journal of Engineering and Technology (IRJET) e-ISSN:2395-0056
Volume: 12 Issue: 04 | Apr 2025 www.irjet.net
Classification
p-ISSN:2395-0072

12 Phylogeneticanalysistree
Table 2. TaxonomicClassificationof Escherichiafergusonii.
Kingdom
Phylum
Class
Order
Family
Bacteria
Pseudomonadota
Gammaproteobacteria
Enterobacterales
Enterobacteriaceae
Genus Escherichia
GenusSpecies
In the initial primary screening for antibacterial activity, Escherichia fergusonii showed a slightly clear zone against two significant pathogens that is, Escherichia coli and Staphylococcus aureus (Fig. 13 &14). Although the zones of inhibition were relatively small, they indicated that E. fergusonii produces microbial compound with antibacterial properties.Basedonthisresult,thebacterialstrainmaynot exhibit strong broad-spectrum antibacterial effects, it does have the potential to slow the growth of certain harmful bacteria.
Escherichiafergusonii

International Research Journal of Engineering and Technology (IRJET) e-ISSN:2395-0056
Volume: 12 Issue: 04 | Apr 2025 www.irjet.net p-ISSN:2395-0072
13 Primaryscreeningofantibacterialactivityagainst
14 Primaryscreeningofantibacterialactivityagainst Escherichiacoli.
3.6 Optimization of growth and antimicrobial compounds production
3.6.1 Effect of pH
The pH levels of the Tryptone Soya Broth (Soybean CaseinDigestMedium)havebeenadjustedto6.5,7.5,and7. Escherichia fergusonii was introduced to the broth medium, and the flasks were shaken and cultured for 7days at 30°C. Following an evaluation of the supernatant's antibacterial activity from cultures cultivated at 6.5, 7 and 7.5, no clear zones of inhibition were observed against Staphylococcus aureus. That shows the different pH values not enhance the productionofantimicrobialcompoundscapableofinhibiting S.aureus underthetestedconditions.
3.6.2 Effect of temperature
After testing the antimicrobial activity of the supernatant broth from cultures grown at different temperatures (00C, 200C,300C&400C),slightzonesofinhibitionwereobserved against Staphylococcus aureus at 0°C (Fig. 15 a) and 20°C (Fig.15b).However,noclearzones ofinhibitionwere seen at 30°C and 40°C. This indicates that lower temperatures may facilitate some level of antibacterial activity against S. aureus, while higher temperatures appear to reduce this effect.

International Research Journal of Engineering and Technology (IRJET) e-ISSN:2395-0056
Volume: 12 Issue: 04 | Apr 2025 www.irjet.net
The antimicrobial activity was tested by incubating 2 flasks encompassingculturemediafor7daysunderlightanddark

3.6.4
The disc diffusion method was performedto test for antimicrobialactivityondays4,5,6,7,8,9,and10afterthe culture was inoculated in growth medium for 10 days as part of the study on the effect of the incubation time. However,noneofthesedaysshowedanyzonesofinhibition, suggesting that the incubation period was not successful in the production of antimicrobial compoundsagainst the pathogensunderexamination.
p-ISSN:2395-0072
conditions. In the dark condition, a slight zone of inhibition was observed (Fig. 16 a), indicating some level of antimicrobial activity. In the light condition, zones of inhibitionnotobserved(Fig.16b).


TryptoneSoyBrothwassuccessfullyinoculatedwiththe E.fergusonii,andthemixturefermentedfor7daysat30°Cin a shaker. After fermentation, the solid biomass was separated from the liquid by centrifuging the culture for 10 minutes at 5000 rpm. After that, a Millipore filter was used to make sure the supernatant was clear of any remaining cellsordebris

International Research Journal of Engineering and Technology (IRJET) e-ISSN:2395-0056
Volume: 12 Issue: 04 | Apr 2025 www.irjet.net
Torecoveranyremainingantibioticcompounds,the200 ml culture filtrate was extracted three times using butanol. Butanolwasaddedtothefiltrateina1:1(v/v)ratio,andthe mixture was agitated for 20 minutes. The aqueous phase was separated from the butanol phase, which most likely included the antibiotic (Fig. 17 & 18). This layer was then evaporated to dryness at 110°C, and the resulting residue had been purified with methanol, yielding 0.071g of brown crudeextractinpowderform(Fig.19).Thisextractisrichin secondary metabolites, potentially containing antimicrobial compoundsforfurtherstudy.


p-ISSN:2395-0072

The antibacterial activity of the crude extract has been assessedbyusingtheagar-welldiffusionmethod.OnMullerHintonagar,20µlofS.aureuswasspreadout.Usingasterile 6mmcork-borer,wellsweremadeandfilled with20µl,30 µl, and 40 µl of the crude metabolite. After 12–16 hours at 4°C, the plate was incubated for the entire night at 37°C. Whenthecrudemetabolitesconcentrationincreased,italso increased the zone of inhibition. In particular, a zone of inhibition of about 0.2 mm was produced by 20 µl of the crude metabolite, while a zone of inhibition of about 0.25 mm was produced by 30 µl. The broadest inhibiting zone, measuring around 0.45 mm, was produced by the highest concentration, 40 µl (Table 3). These results show that the crudeextracthasantibacterialactivityagainstS.aureus(Fig. 20).
Fig. 20 Antibacterialactivityshowedzonesofinhibitionfor 20µl,30µl,and40µlofcrudemetaboliteagainst Staphylococcusaureus.

International Research Journal of Engineering and Technology (IRJET) e-ISSN:2395-0056
Volume: 12 Issue: 04 | Apr 2025 www.irjet.net
Table 3. EffectofCrudeMetaboliteConcentrationon AntimicrobialActivity
20
30
40
Footnote: µL (microliter) represents the volume of crude metabolites used, and mm (millimeter) denotes the diameterofthezoneofinhibition.
The significance of researching unconventional bacterial strains for their ability to produce antibiotics has been demonstrated by the study we conducted of Escherichia fergusonii. The methodologies applied, which include collecting soil samples, isolating bacterial colonies, and executing16SrRNAsequencingformolecularidentification, adhere to standard protocols, ensuring the consistency of theobservations.Theidentificationof E. fergusonii asarodshaped, Gram-negative bacterium with moderate antibacterial activity against Staphylococcus aureus and E. coli is consistent with previous studies on its modest but substantial antimicrobial properties (Awais et al., 2007; Ram,2014).
However, their inhibitory properties are not as effective as those produced by Streptomyces or comparable standard antibiotic-producing bacteria, the small zones of inhibition seen in primary and secondary screening indicates the potential of antibiotic a synthesis process. These results emphasize the importance of optimization, which was demonstratedthroughstudies(Salimetal. 2017)andSingh et al. 2012). Lower temperatures and dark conditions significantly improved inhibitory zones, indicating that external variables play an essential part in metabolite growth, even though variations in pH and incubation times hadnoeffectonantibacterialactivity.
Utilizing butanol for extractionof secondarymetabolites produced a crude extract having concentration-dependent antibacterial activity (Al-Reubay et al., 2023). The broadest zone of inhibition was produced by the highest amount (40 µl), supporting the effectiveness of butanol extraction in isolating compounds that are bioactive. The crude extract yield (0.071 g) emphasizes the necessity for further advancement in growing circumstances and methods of extractioninordertooptimizeyield.
p-ISSN:2395-0072
All things considered, these results add to the comprehension of bacterial strains isolated from soil and their ability to produce antibiotics. Although E. fergusonii exhibits modest behavior, the study provides potential for additional investigation, especially into improving metabolite yield, maximizing growth conditions, and determiningtheprecisebioactivecompoundsthatprovideit antibiotic properties. These findings correspond to alignmentwithinternationalinitiativestoaddressantibiotic resistance through the identification of novel antimicrobial medicines(Khattabetal.,2016;Nairetal.,2022).
Escherichia fergusonii was successfully isolated, identified, and its ability to produce antibiotics assessed from soil samples obtained from a university campus. The bacterium classification as a Gram-negative rod has been confirmed through biochemical analysis and 16S rRNA sequencing. The crude extract from butanol extraction showed concentration-dependent inhibition, signifying the existenceofbioactivecompounds,eventhoughprimaryand secondary screenings showed moderate antibacterial activityagainst Escherichiacoli and Staphylococcusaureus
Based on optimization studies, the production of secondary metabolites is significantly affected by environmental parameters including temperature and light phases, with dark incubation and lower temperatures increasing antibacterial activity. The results emphasize the potential of E. fergusonii as a source for novel antibacterial compounds,despitethecrudeextract'sconstrainedyield.
This research enhances our understanding of the soil microbiology as an important source of bacteria that produce antibiotics and emphasizes the necessity of additional research and improvement of less commonly recognizedbacterialstrains.Inordertoaddressthepressing global issue of antibiotic resistance, more research focusing on the structural clarification of bioactive compounds and their modes of action could reveal up the possibilities to noveltherapeuticapplications.
We would like to acknowledge our guide Dr. Ravindra Kale, Assistant Professor, Department of Biotechnology, for his invaluable guidance and support throughout this study. I also extend my gratitude to Dr. A.S. Khemnar, Director, for providingthenecessaryinfrastructureandresources,andto Dr. S.N. Harke, HOI, for their continuous support during the researchprocess.

International Research Journal of Engineering and Technology (IRJET) e-ISSN:2395-0056
[1] Al-Rubaye TS, Mohsen BA, Subhi SA, Risan MH. Biochemical studies on antibiotic production from Streptomyces griseus. J Popul Ther Clin Pharmacol. 2023;30(2):240-248.
[2] Arul Jose P, Sivakala KK, Jebakumar SRD. Formulation and statistical optimization of culture medium for improved production of antimicrobial compound by Streptomyces sp. JAJ06. Int J Microbiol. 2013;2013(1):526260.
[3] Awais M, Shah AA, Hameed A, Hasan F. Isolation, identification and optimization of bacitracin produced by Bacillus sp. PakJBot. 2007;39(4):1303.
[4] BaileyWR,ScottEG. DiagnosticMicrobiology:ATextbook for the Isolation and Identification of Pathogenic Microorganisms. 1966.
[5] Bhavana M, Talluri VP, Kumar KS, Rajagopal SV. Optimization of culture conditions of Streptomyces carpaticus (MTCC-11062) for the production of antimicrobial compound. Int J Pharm Pharm Sci. 2014;6(8):281-285.
[6] Buchanan RE, Gibbons NE, eds. Bergey's Manual of DeterminativeBacteriology. 8thed.1974.
[7] Farhadi F, Khameneh B, Iranshahi M, Iranshahy M. Antibacterial activity of flavonoids and their structure–activity relationship: an updated review. Phytother Res. 2019;33(1):13-40.
[8] Gaastra W, Kusters JG, Van Duijkeren E, Lipman LJA. Escherichia fergusonii Vet Microbiol. 2014;172(1-2):712.
[9] Glover B, Wentzel J, Jenkins A, Van Vuuren M. The first report of Escherichia fergusonii isolated from nonhumanprimatesinAfrica. OneHealth. 2017;3:70-75.
[10] Janda JM, Abbott SL. 16S rRNA gene sequencing for bacterial identification in the diagnostic laboratory: pluses, perils, and pitfalls. J Clin Microbiol. 2007;45(9):2761-2764.
[11] Khalid ZZ, Rashid F, Ashraf A, Iqbal MN, Hussain F. Isolation and screening of antibiotic-producing bacteria fromsoilinLahorecity. PSMMicrobiol. 2016;1(1):1-4.
[12] Khattab AI, Babiker EH, Saeed HA. Streptomyces: isolation, optimization of culture conditions, and extraction of secondary metabolites. Int Curr Pharm J. 2016;5(3):27-32.
[13] Kumar PS, Raj JPP, Duraipandiyan V, Ignacimuthu S. AntibacterialactivityofsomeactinomycetesfromTamil Nadu, India. Asian Pac J Trop Biomed. 2012;2(12):936943.
[14] Kumari M, Myagmarjav BE, Prasad B, Choudhary M. Identification and characterization of antibioticproducing Actinomycetes isolates. Am J Microbiol. 2013;4(1):24.
Volume: 12 Issue: 04 | Apr 2025 www.irjet.net p-ISSN:2395-0072 © 2025, IRJET | Impact Factor value: 8.315 | ISO 9001:2008
[15] Makut M, Owolewa O. Antibiotic-producing fungi present in the soil environment of Keffi metropolis, NasarawaState,Nigeria. Eubacteria. 2011;10(18):19.
[16] NairRV,ManikandanR,MathanmohunM,SelvakumarS. Isolation, screening, and optimization of penicillindegrading bacterial strains from poultry manure, municipal, and industrial waste. Res J Agric Sci Int J. 2022;13(1):208-210.
[17] Patel JB. 16S rRNA gene sequencing for bacterial pathogen identification in the clinical laboratory. Mol Diagn. 2001;6:313-321.
[18] PratapSinghA,BSinghR,MishraS.Studiesonisolation and characterization of antibiotic-producing microorganisms from industrial waste soil samples. OpenNutraceuticalsJ. 2012;5(1).
[19] Raaijmakers JM, Vlami M, De Souza JT. Antibiotic production by bacterial biocontrol agents. Antonie Van Leeuwenhoek. 2002;81:537-547.
[20] Ram L. Optimization of medium for the production of streptomycin by Streptomyces griseus Int J Pharm Sci Invention. 2014;3:1-8.
[21] RisanMH,JafarRA,SubhiSA.Isolation,characterization, and antibacterial activity of a rare Actinomycete: Saccharopolyspora sp.inIraq.
[22] Rokem JS, Lantz AE, Nielsen J. Systems biology of antibiotic production by microorganisms. Nat Prod Rep. 2007;24(6):1262-1287.
[23] Salim FM, Sharmili SA, Anbumalarmathi J, UmamaheswariK.Isolation, molecularcharacterization, and identification of antibiotic-producing Actinomycetes fromsoilsamples. JApplPharmSci. 2017;7(9):69-75.
[24] SimmonsK,IslamMR,RempelH,BlockG,ToppE,Diarra MS. Antimicrobial resistance of Escherichia fergusonii isolated from broiler chickens. J Food Prot. 2016;79(6):929-938.
[25] Sivarajan A, Shanmugasundaram T, Sangeetha M, Radhakrishnan M, Balagurunathan R. Screening, production, and characterization of biologically active secondary metabolite(s) from marine Streptomyces sp. PA9 for antimicrobial, antioxidant, and mosquito larvicidalactivity.
[26] Tang B, Chang J, Chen Y, Lin J, Xiao X, Xia X, Zhao G. Escherichia fergusonii, an underrated repository for antimicrobial resistance in food animals. Microbiol Spectr. 2022;10(1):e01617-21.